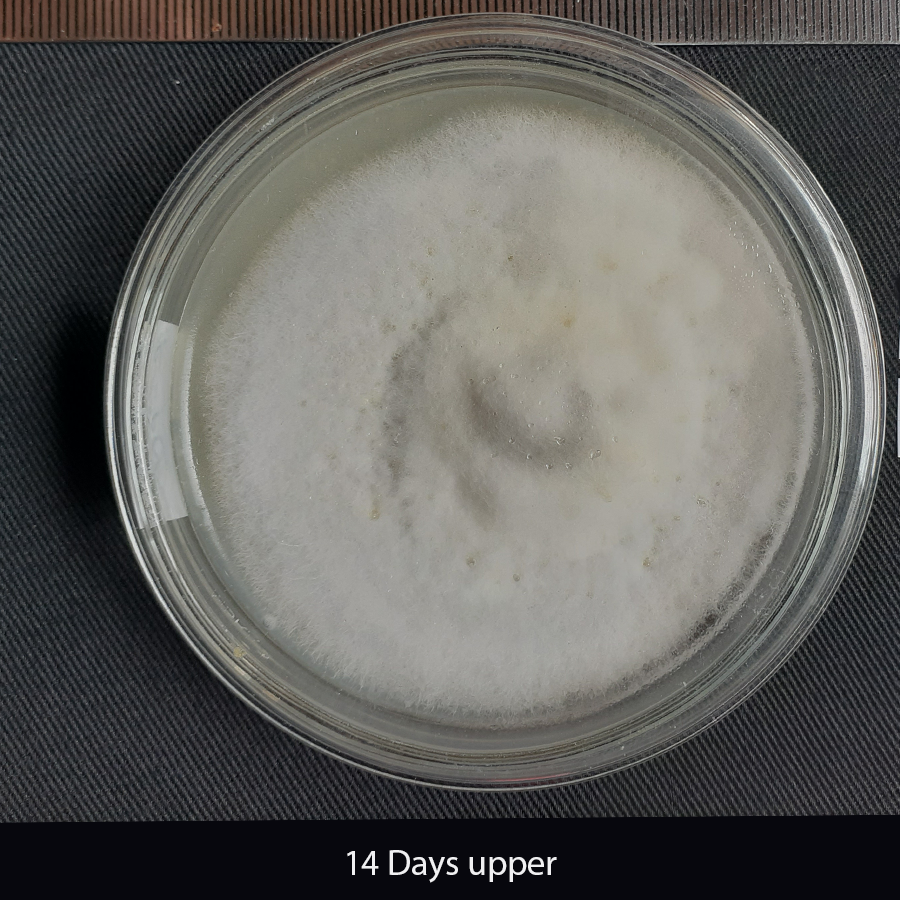

Strain - R-P4
| Mating type | Mat 1-2 |
| Climate zone | Intermediate zone |
| Host | Finger millet |
| Infected organ | Neck blast |
| Agroecology | IM3b |
| GPS Location | 7.472489, 80.650826 |
| After 7 Days | After 14 Days | |
| Dorsal surface colony texture on Oat meal | Flat, dense | Fluffy, raised,dense |
| Dorsal surface colony colour on Oat meal | White, Ash (+) | Complete white |
| Ventral surface colony colour on Oat meal | Moderate pigmentation |
Avirulance Gene Profile
| Avr 1 CO39 | AVR Pi9 | Avr-Pia | AVR-Pib | AVR-Pikz | Avr-Pit | ZZ41 | MOPI54 | ACE1 | Avr-Pita | Avr-Pik | Avr-Piz-t | Avr-Pi15 |
|---|---|---|---|---|---|---|---|---|---|---|---|---|
| Present | Present | Present | Present | Absent | Present | Present | Present | Present | Absent | Present | Absent | Present |